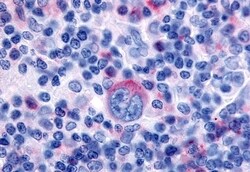
Invitrogen GPR65 Polyclonal Antibody 50 &mu;g; Unconjugated:Antibodies,
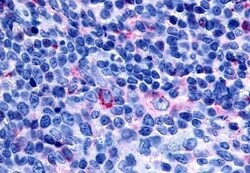
Invitrogen GPR65 Polyclonal Antibody 50 &mu;g; Unconjugated:Antibodies,

missing translation for 'onlineSavingsMsg'
Learn More
Learn More
Invitrogen™ GPR65 Polyclonal Antibody
Rabbit Polyclonal Antibody
Brand: Invitrogen™ PA533753
This item is not returnable.
View return policy
Description
Percent identity with other species by BLAST analysis: Human, Gorilla, Gibbon, Monkey, Marmoset, Mouse, Rat, Dog, Bat, Panda, Horse, Pig (94%).
GPR65 also known as TDAG8 is a transmembrane protein belonging to the G protein coupled receptor super family with 337-amino acid and 90% similarity and 81% identity in the 7 transmembrane domains of its mouse homolog. It has 3 potential N-linked glycosylation sites and is expressed predominantly in lymphoid organs and cancer tissues with increased expression during activation-induced death of T-cell hybridomas. Two major transcripts of 4.5 kb and 1.8 kb are found in peripheral blood leukocytes and functions as a novel proton-sensing receptor. It couples to adenylyl cyclase and psychosine and is also actively involved in the establishment of immunological autotolerance. GPR65 has a role in cellular transformation by RhoA activation and actin rearrangement under conditions accompanying tissue acidosis.
Specifications
| GPR65 | |
| Polyclonal | |
| Unconjugated | |
| GPR65 | |
| Dig1; G protein-coupled receptor 65; Gpcr25; Gpr65; G-protein coupled receptor 25; G-protein coupled receptor 65; hTDAG8; Psychosine receptor; T cell death associated protein 8; T-cell death-associated gene 8 protein; TDAG8 | |
| Rabbit | |
| Antigen affinity chromatography | |
| RUO | |
| 8477 | |
| Store at 4°C short term. For long term storage, store at -20°C, avoiding freeze/thaw cycles. | |
| Liquid |
| Immunohistochemistry (Paraffin) | |
| 1 mg/mL | |
| PBS with 0.1% sodium azide | |
| Q8IYL9 | |
| GPR65 | |
| Synthetic 16 amino acid peptide from 1st cytoplasmic domain of human GPR65. | |
| 50 μg | |
| Primary | |
| Human | |
| Antibody | |
| IgG |
Product Content Correction
Your input is important to us. Please complete this form to provide feedback related to the content on this product.
Product Title
Spot an opportunity for improvement?Share a Content Correction